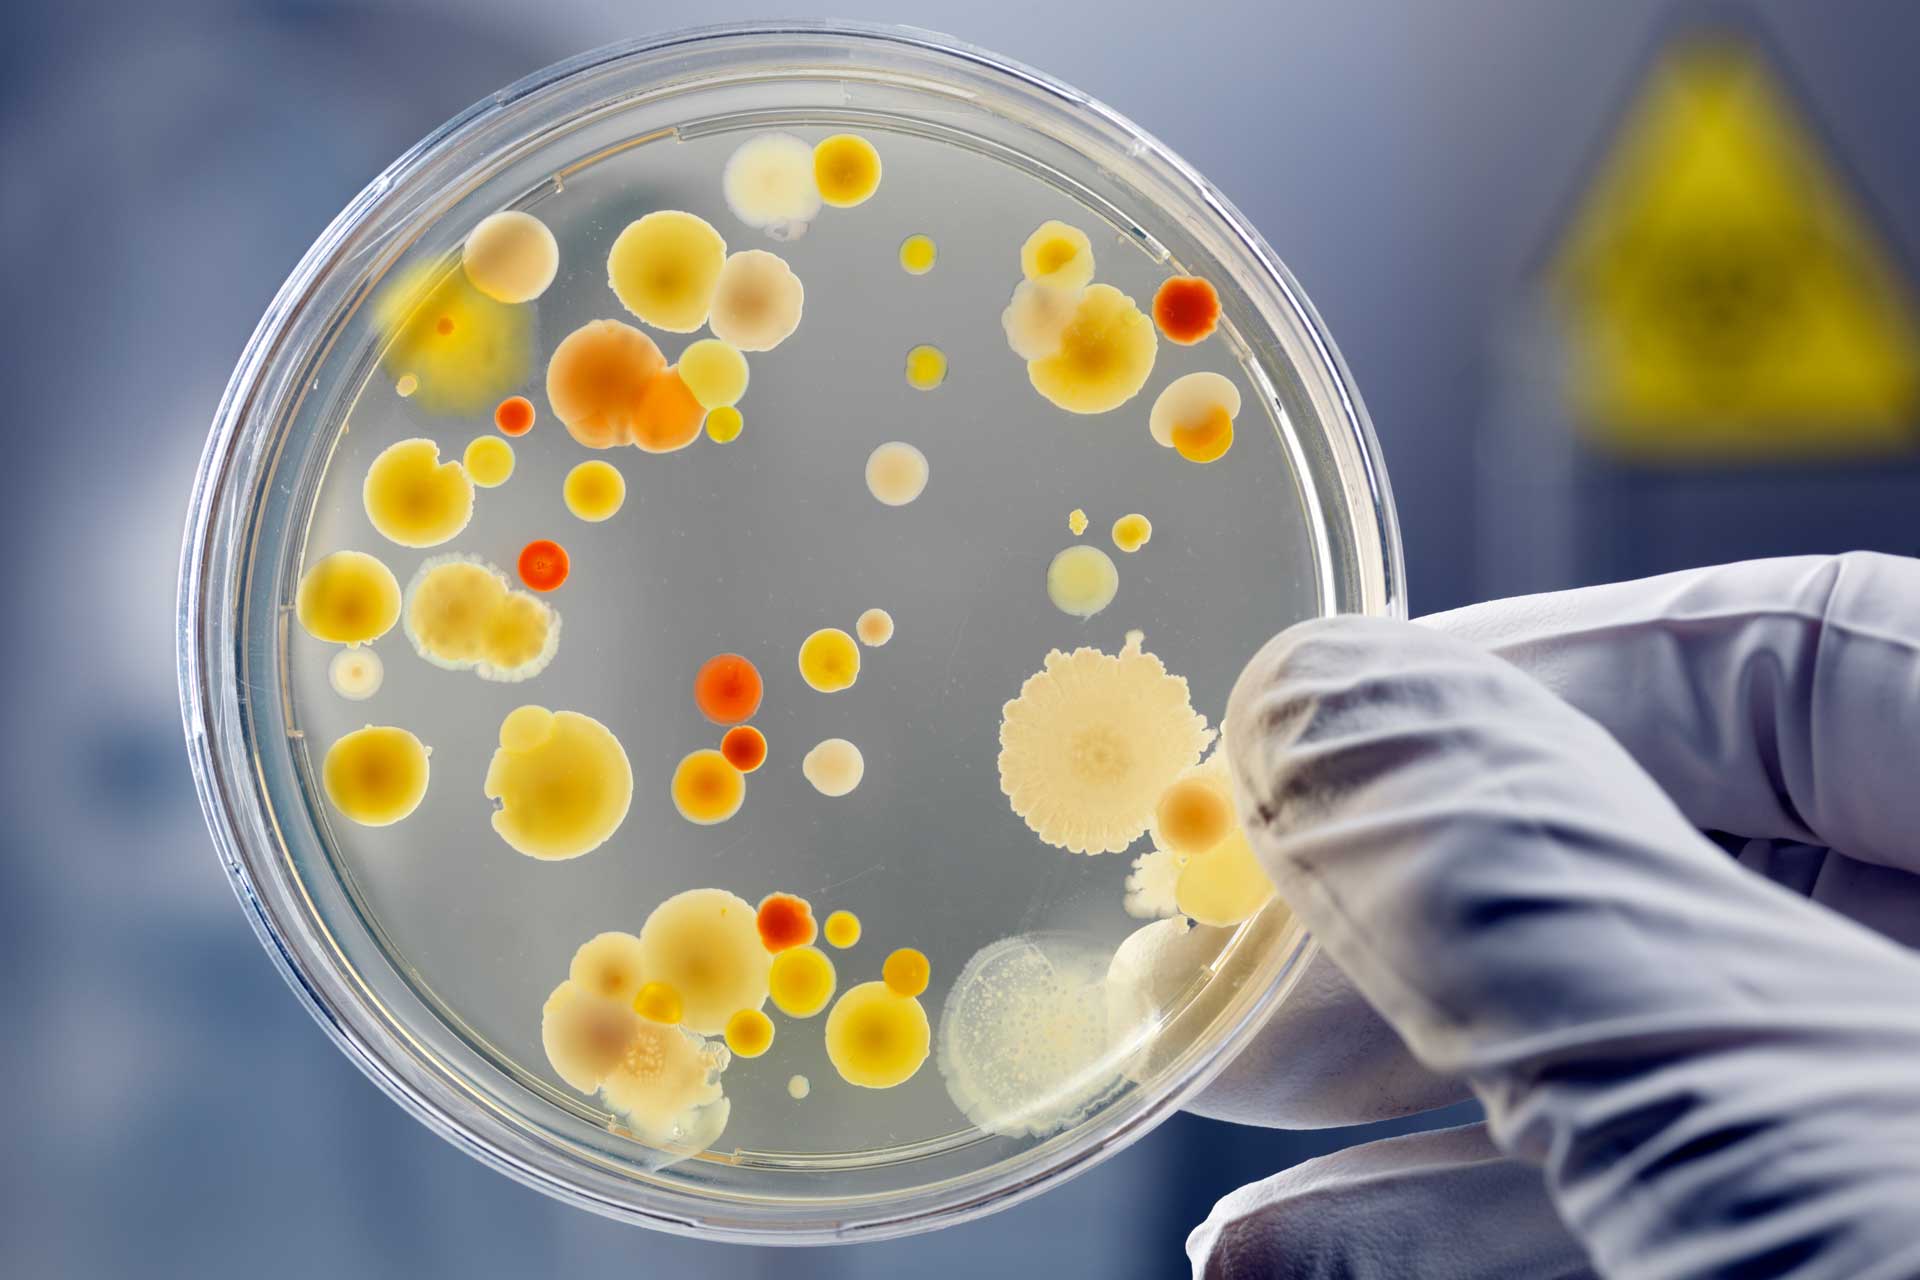

What is the role of the microbiome in allergic reactions Can probiotics help with infant colic
In Stock
$34.99
$29.99
Shipping and Returns Policy
- Deliver to United States » Shipping Policy «
- - Shipping Cost: $5.99
- - Handling time: 2-3 business days
- - Transit time: 7-10 business days
- Eligible for » Returns & Refund Policy « within 30 days from the date of delivery
Find similar items here:
what are probiotics
- What are some documentaries or books about the gut microbiome What are some online communities for people interested in gut health
- Can I get enough probiotics from my diet alone
- How can I support my child's gut health
- Can probiotics help with ADHD
- How can I make informed food choices for better gut health What is the role of digestive enzymes
- How long after antibiotics should I start taking probiotics Can stress affect my gut microbiome
- What are the different strains of yeast in probiotics
- Can probiotics reduce inflammation
- What are some strategies for improving sleep and gut health
- How does the small intestine absorb nutrients What is the role of the pancreas in digestion
-
Next Day Delivery by USPS
Find out more
Order by 9pm (excludes Public holidays)
$11.99
-
Express Delivery - 48 Hours
Find out more
Order by 9pm (excludes Public holidays)
$9.99
-
Standard Delivery $6.99 Find out more
Delivered within 3 - 7 days (excludes Public holidays).
-
Store Delivery $6.99 Find out more
Delivered to your chosen store within 3-7 days
Spend over $400 (excluding delivery charge) to get a $20 voucher to spend in-store -
International Delivery Find out more
International Delivery is available for this product. The cost and delivery time depend on the country.
You can now return your online order in a few easy steps. Select your preferred tracked returns service. We have print at home, paperless and collection options available.
You have 28 days to return your order from the date it’s delivered. Exclusions apply.
View our full Returns and Exchanges information.
Our extended Christmas returns policy runs from 28th October until 5th January 2025, all items purchased online during this time can be returned for a full refund.
No reviews yet. Only logged in customers who have purchased this product may leave a review.